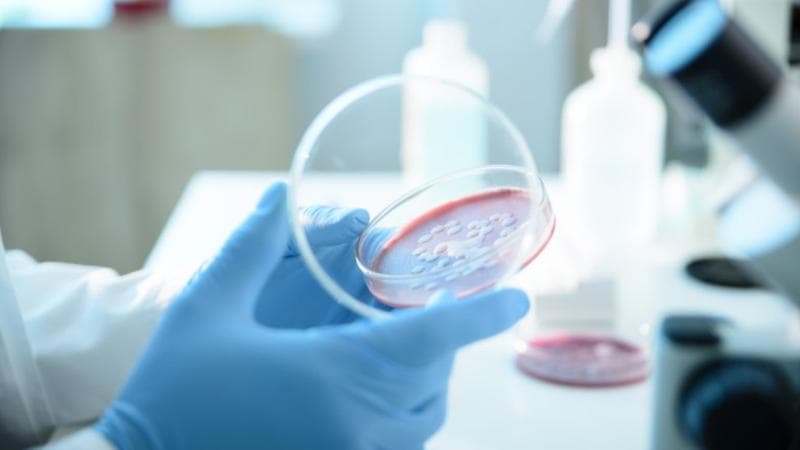
Ce este Serratia marcescens, bacteria care ar fi provocat moartea a şase copii la spitalul „Sfânta Maria” din Iaşi

Sănătatehttps://unimedia.info/
Ce este Serratia marcescens, bacteria care ar fi provocat moartea a şase copii la spitalul „Sfânta Maria” din Iaşi
Serratia marcescens este o bacterie din familia Enterobacteriaceae. Deși a fost considerată inițial o bacterie fără relevanță patogenă, în prezent este asociată frecvent cu infecțiile nosocomiale, afectând pacienți vulnerabili, în special pe cei spitalizați pe termen lung sau cu imunitate compromisă. Este un bacil Gram-negativ, izolat de rutină din sânge și din plăgi pe medii de cultură precum agar-sânge, dar și din tractul respirator sau urinar, utilizând medii selective precum agar MacConkey sau agar cromogen. Un caz notoriu a avut loc în SUA, în martie 2011, când autoritățile sanitare au raportat prezența bacteriei în mai multe spitale din statul Alabama. Investigațiile au sugerat contaminarea unor soluții perfuzabile folosite pentru hrănirea intravenoasă a pacienților. Rezultatul a fost grav: nouă pacienți au murit, iar alți zece au fost infectați. Toți cei 19 pacienți afectați fuseseră hrăniți intravenos în instituții publice de sănătate. Chiar dacă legătura directă între perfuzii și decese nu a putut fi dovedită complet, episodul a confirmat că Serratia marcescens se găsește frecvent în mediu spitalicesc și poate provoca focare severe de infecții nosocomiale, dificil de controlat din cauza rezistenței sale la multe antibiotice uzuale. Cât de periculoasă este Serratia marcescens, cum se manifestă și cum se răspândește „Este o bacterie care, inițial, când a fost descoperită acum 150 de ani, era considerată banală, saprofită. Ulterior s-a constatat că produce mai ales în cazul pacienților care au și alte afecțiuni, așa-numitele infecții nosocomiale, și produce fie infecții urinare, rezistente la tratament, pentru că bacteria a devenit între timp și multi rezistentă la tratament. Dar sunt și cazuri în care se răspândește și poate să producă sepsis sau septicemie. Problema legată de această bacterie este că este rezistentă în mediu, se găsește mai ales la nivelul instalațiilor sanitare, care trebuie curățate foarte bine cu produse pe bază de clor, ca să elimine sau să reducă riscul de infecție", a declarat pentru Observator fostul ministru al Sănătății, Alexandru Rafila. Cum se compară cu celelalte bacterii Pseudomonas, Klebsiella? „Proporția de infecții nosocomiale, cel puțin în SUA, produsă de Serratia este undeva între 1-2% din totalul infecțiilor. Deci incidența infecțiilor cu Serratia este mai mică decât cele cu Klebsiella, dar este la fel de periculoasă. La Iași, discutăm de copii mici sau chiar foarte mici, de câteva zile. Ei au fost testați inițial pentru a afla dacă existau astfel de bacterii în momentul internării, și, din câte știu, la majoritatea nu a existat. E clar că trebuie găsită sursa. Discutăm de un focar: de la trei cazuri în sus este un focar. Vorbim de 9 cazuri și câteva decese în septembrie, ceea ce este îngrijorător. Este clar că în acest spital trebuie rezolvată probabil o problemă de identificarea sursei și aplicarea măsurilor de dezinfecție înaltă. Este un spital nou acolo, nu este un spital vechi, deci este clar că ceva se întâmplă în spital și, din câte știu eu, atât Centrul Regional de Sănătate Publică de la Iași s-a implicat în evaluarea situației și acordarea de asistență celor de la spital, cât și Direcția de Sănătate Publică Iași”, a mai precizat Rafila. Care este procedura în cazul infecției cu Serratia „Secția nu se închide după un caz. Focarul este de la 3. Poate să fie un caz întâmplător...dar separarea pacienților, dacă există colonizări sau infecții, este esențială. Aici este o secție care are 44 de paturi, este o secție mare de terapie intensivă, în două locații, și se pot găsi soluții pentru organizarea activității și pentru aplicarea măsurilor de curățenie şi dezinfecție riguroasă în fiecare dintre locații", a mai declarat Rafila. Ministerul Sănătății din România a anunțat că la Spitalul de Copii „"Sfânta Maria” din Iași nouă copii au fost infectați cu bacteria Serratia marcescens, iar șase dintre ei au murit. Prima infecție ar fi apărut pe 13 septembrie, dar a fost raportată cu întârziere.
**Sursa articolului:** Acest material a fost adaptat din articolul original publicat pe [unimedia.info](https://unimedia.info/ro/news/fa15180a5079384a/ce-este-serratia-marcescens-bacteria-care-ar-fi-provocat-moartea-a-sase-copii-la-spitalul-sfanta-maria-din-iasi.html?utm_source=rss&utm_medium=rss&utm_campaign=rss). Vă încurajăm să consultați sursa completă pentru mai multe detalii și context suplimentar.
Sursă: https://unimedia.info/ • Vezi articolul original →
Partajează:


